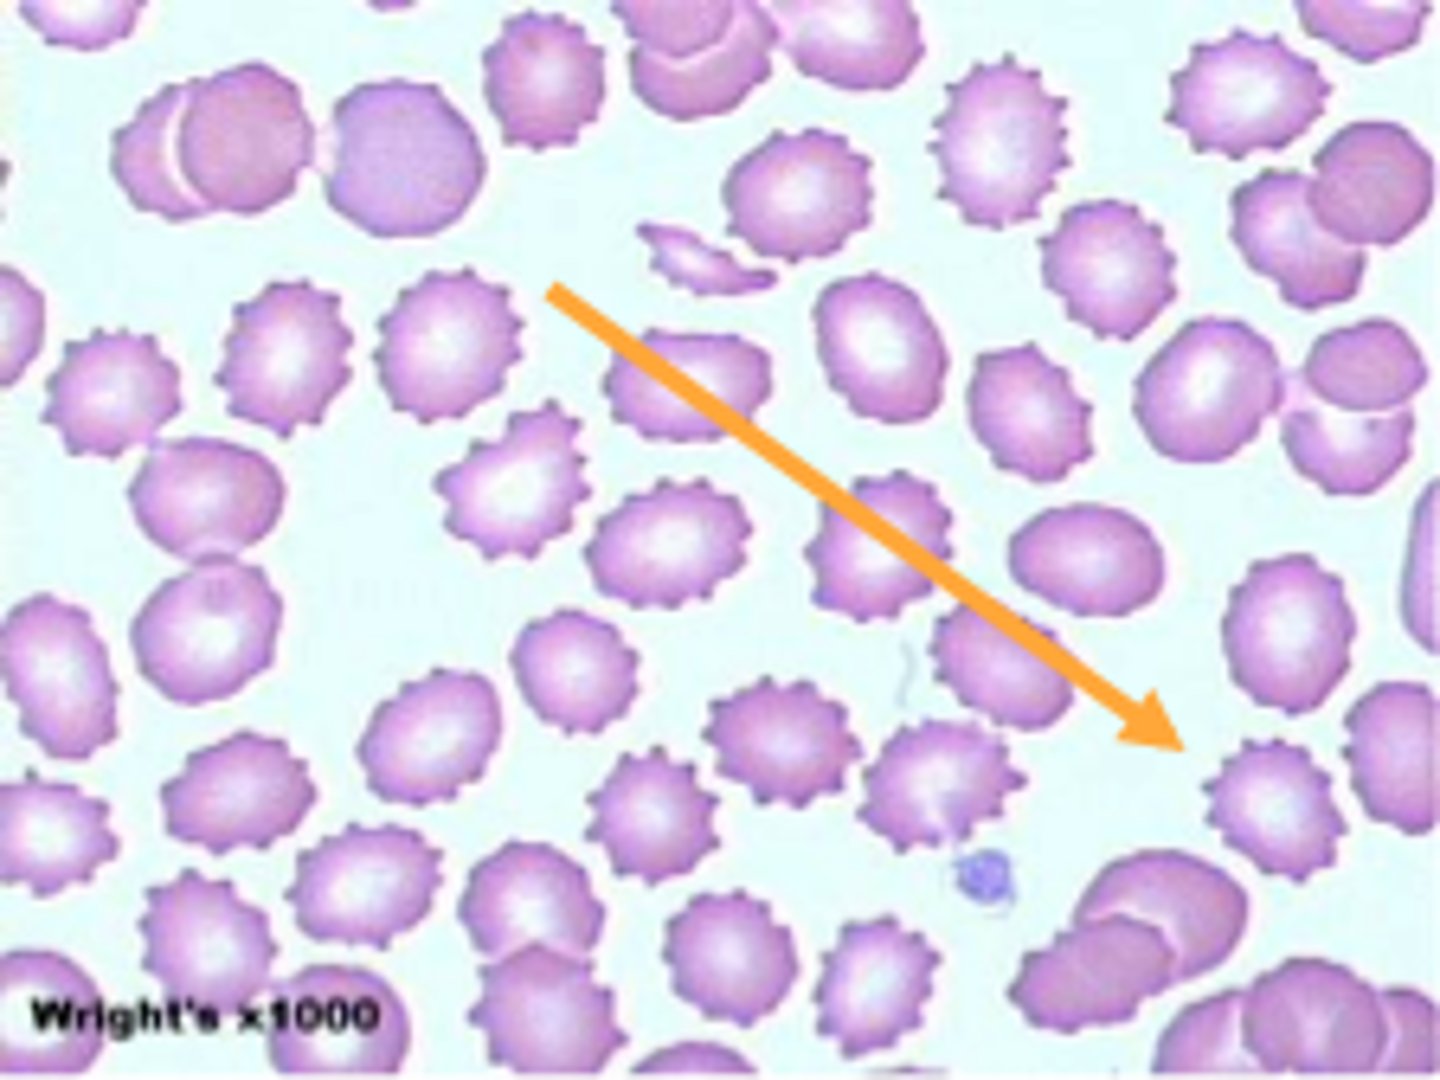
<p>- even projections on membrane (burr cell)</p><p>- human error</p>
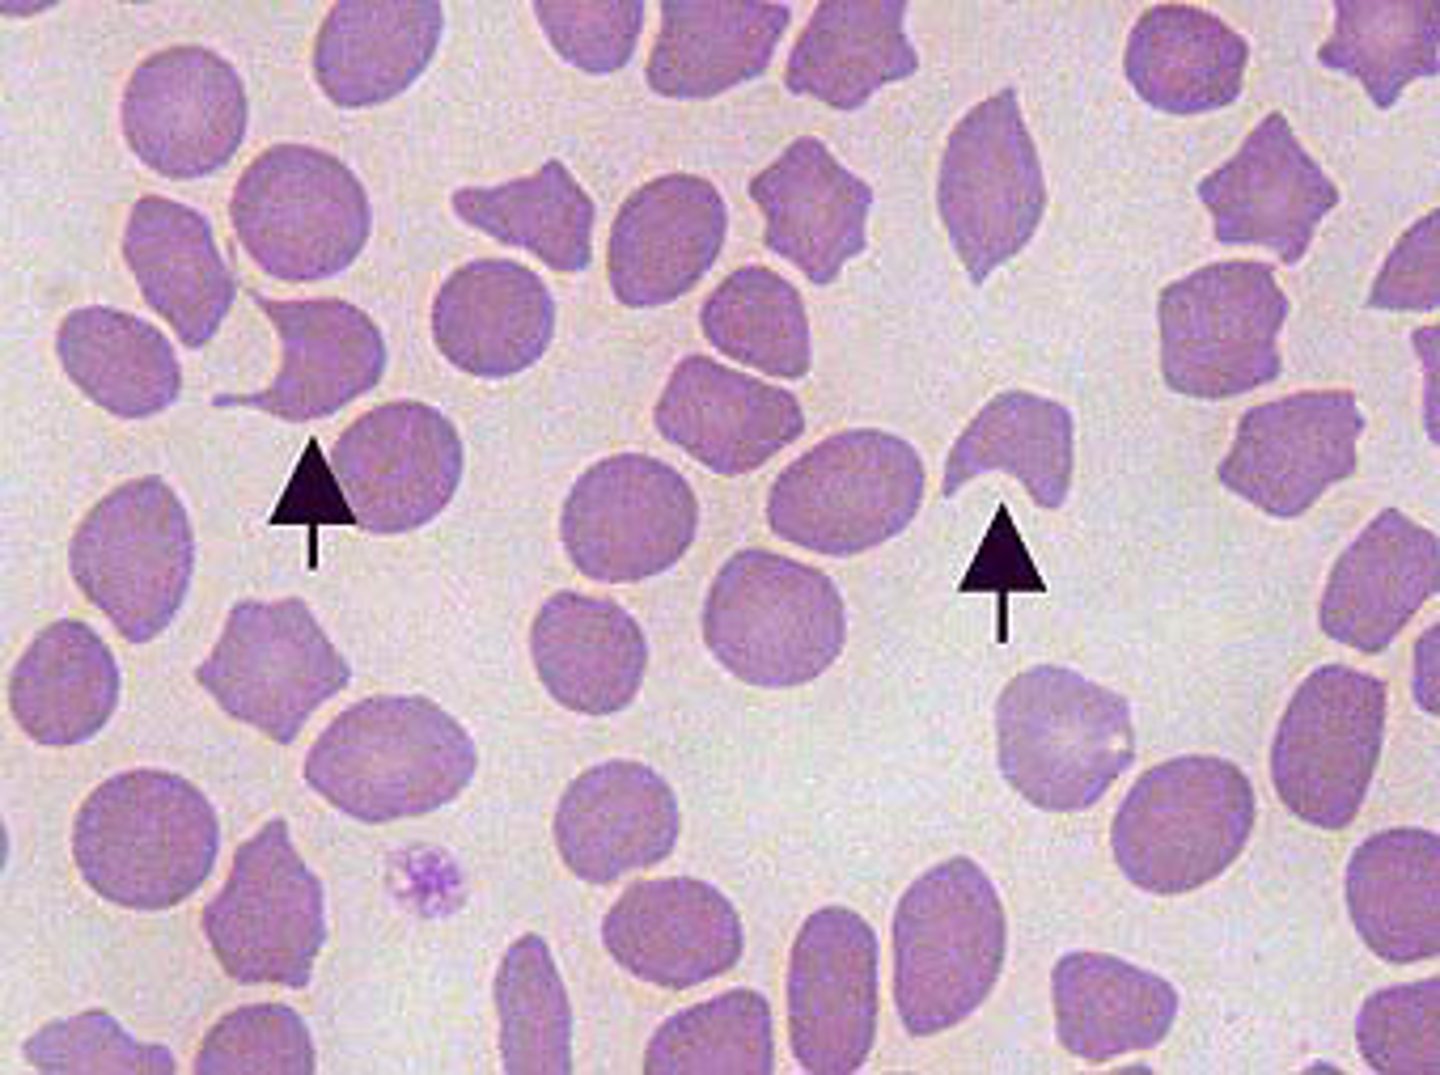
<p>- blister cell</p><p>- liver issues, BM issue, 2nd to anemia</p>
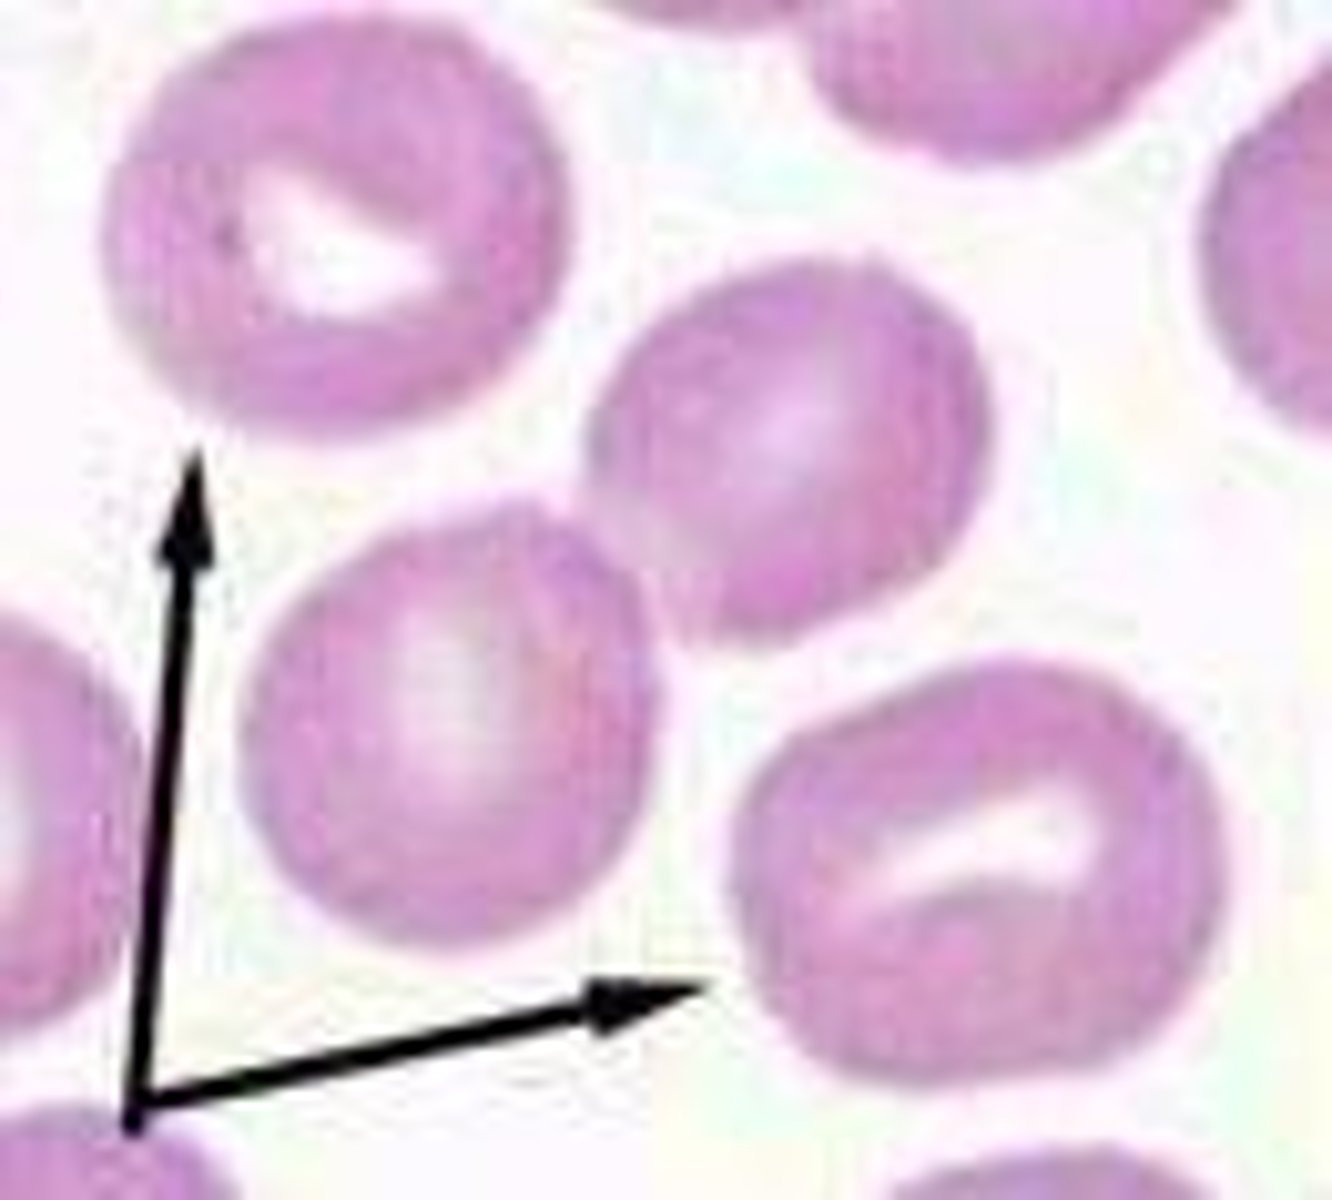
knowt flashcard image
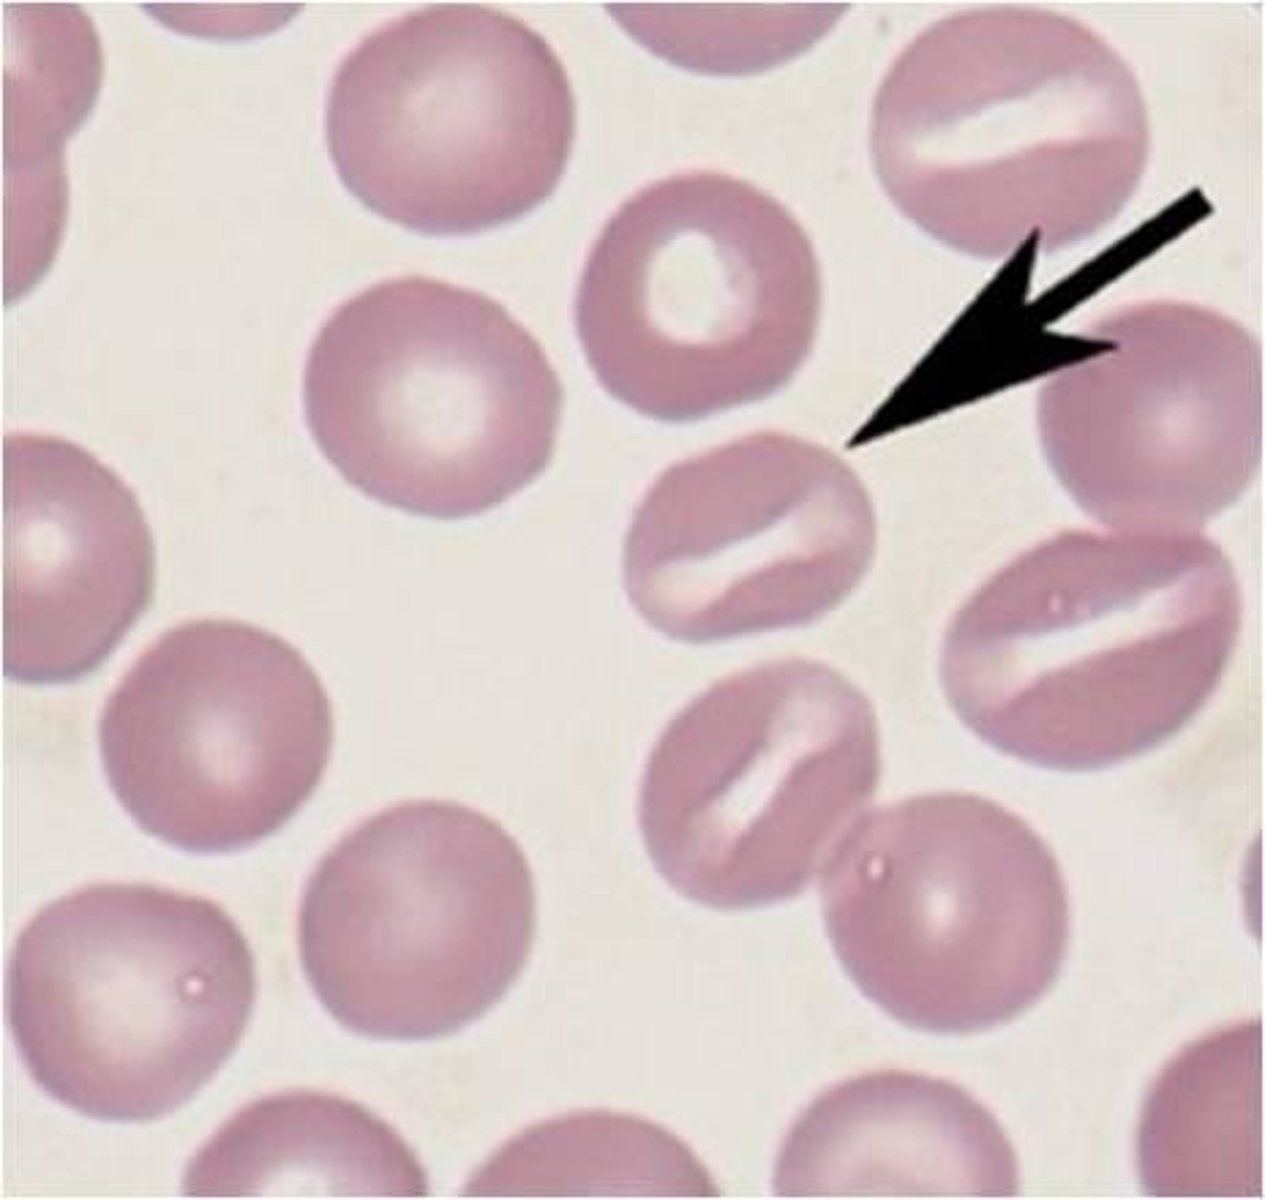
<p>knizocyte</p>
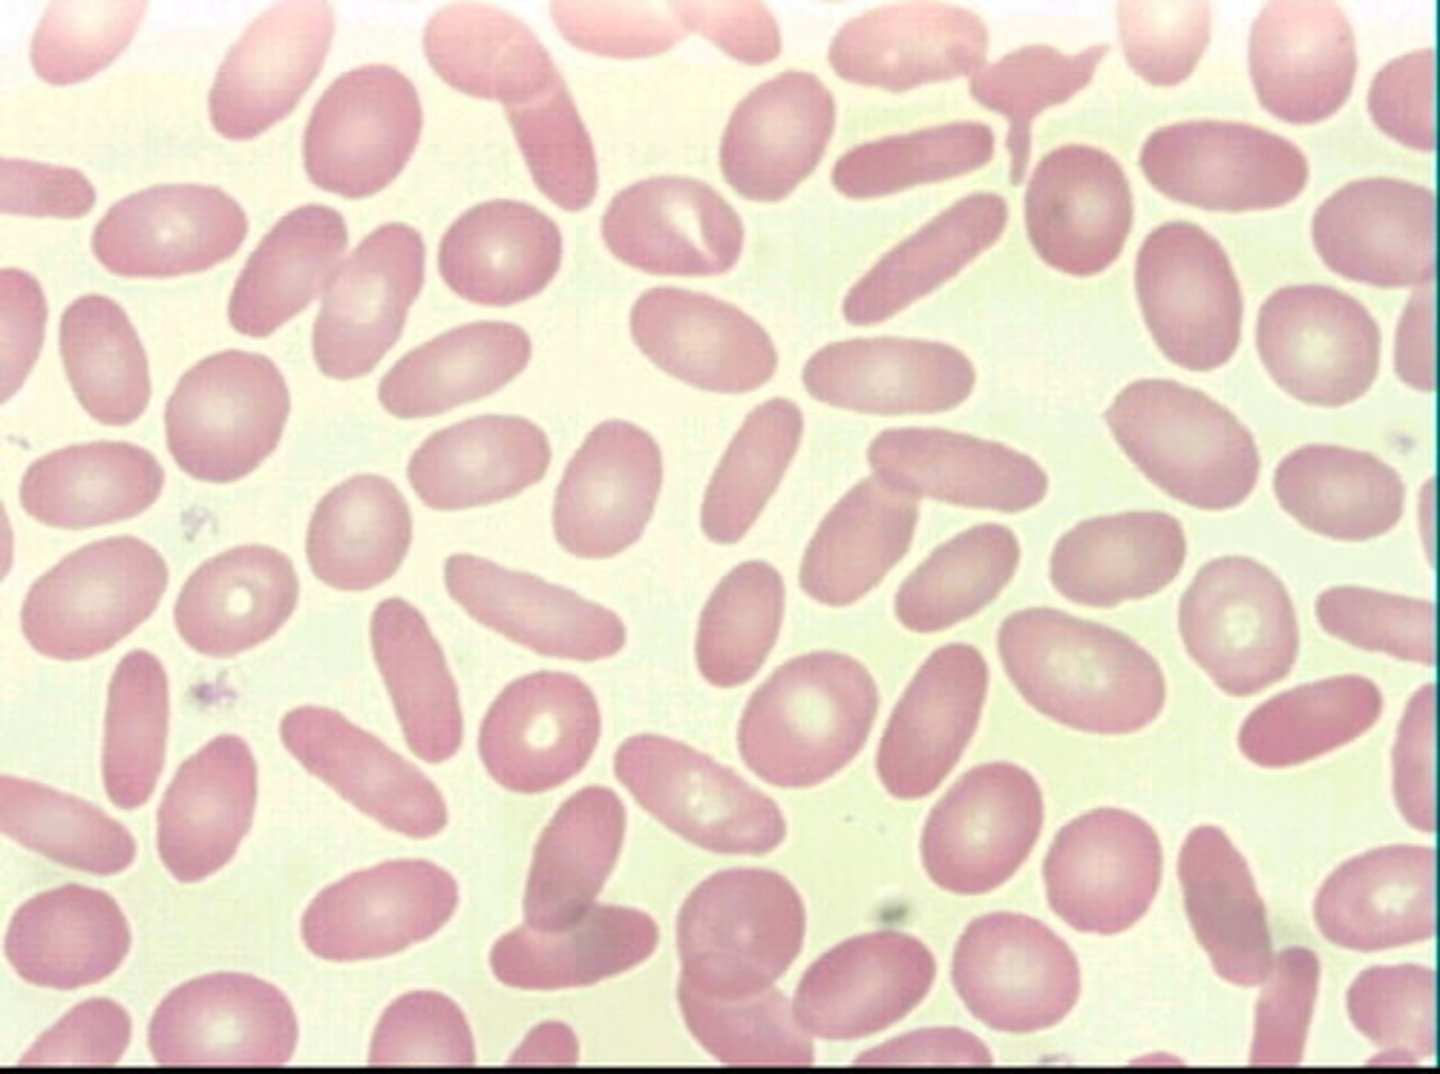
<p>- ovalocyte</p><p>- liver/kidney disease</p>
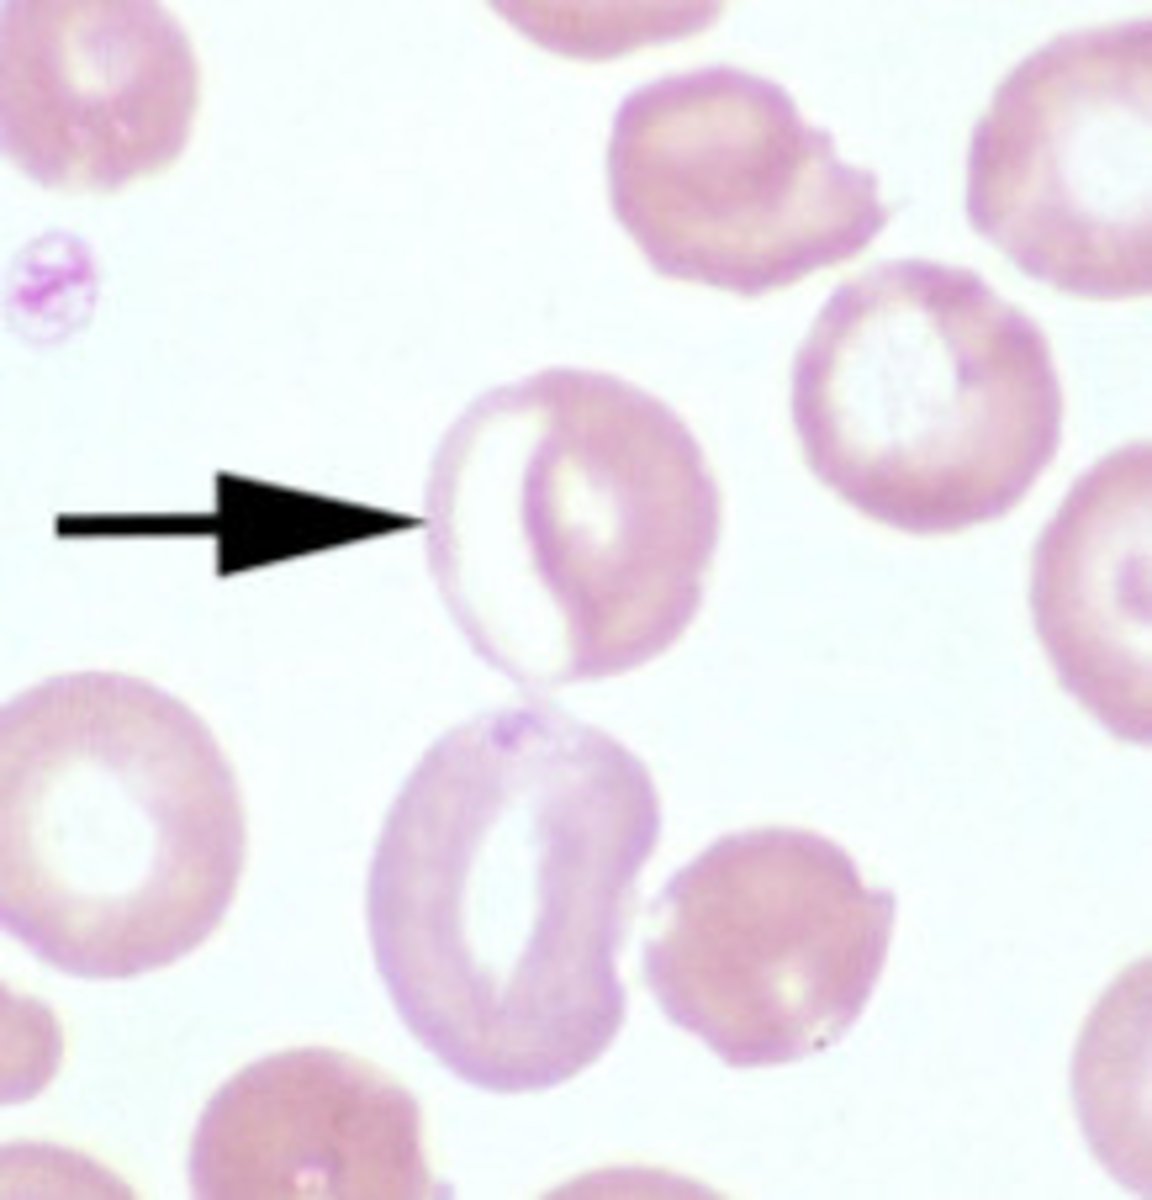
<p>diabetes/cancer/toxins</p>
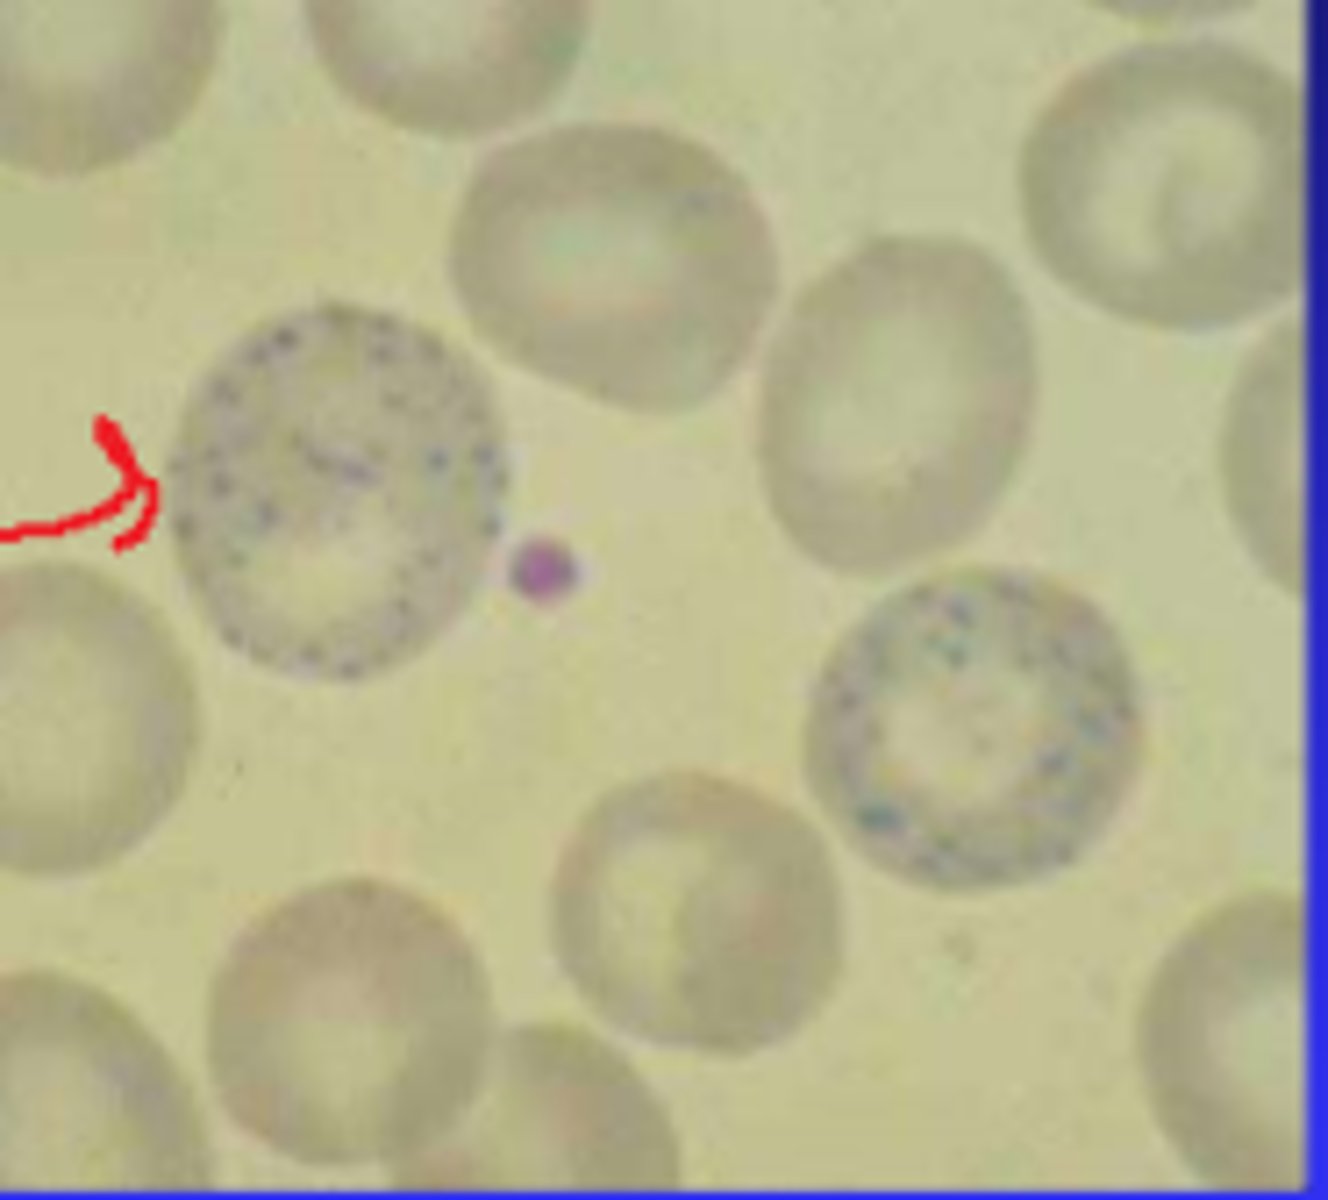
<p>- dark speckles</p><p>- rumintants/cats with anemia</p>
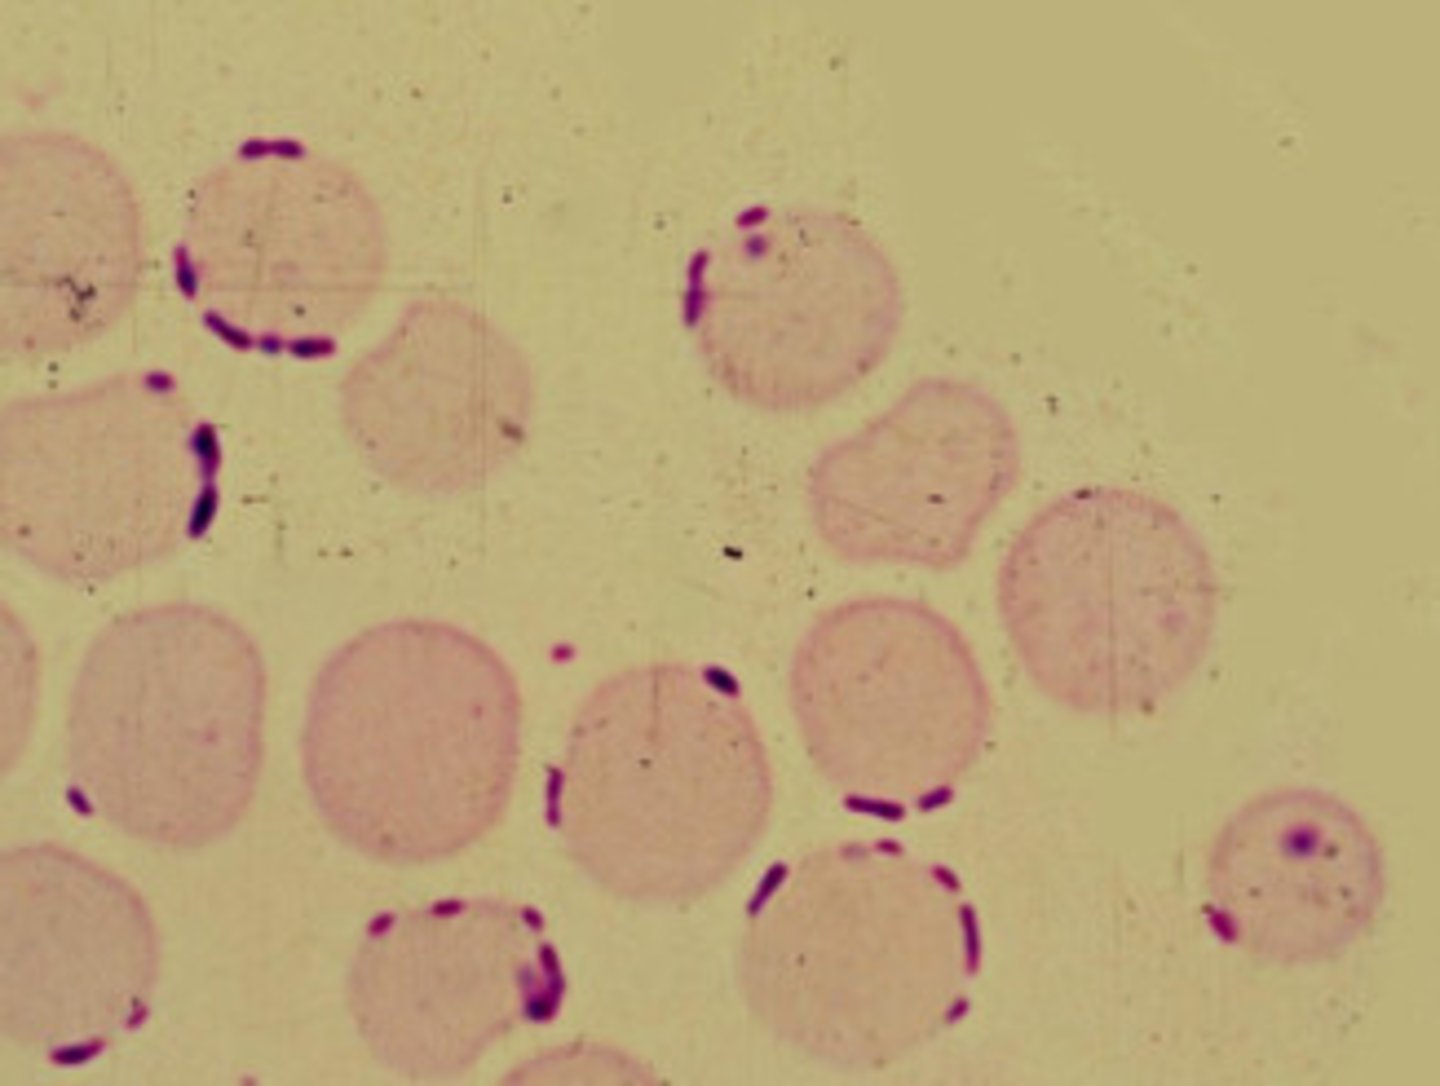
<p>- found on membrane</p><p>- may trigger immune response</p>

1/20
Looks like no tags are added yet.
Name | Mastery | Learn | Test | Matching | Spaced | Call with Kai |
|---|
No analytics yet
Send a link to your students to track their progress
what is a poikilocyte
variation in shape
Schistocyte
RBC fragment
- associated with DIC

Acanthocyte
- Uneven projections on membrane (Spurr cell)
- liver disease

Echinocyte
- even projections on membrane (burr cell)
- human error
Keratocyte
- blister cell
- liver issues, BM issue, 2nd to anemia
spherocyte
- only in dogs
- auto immune disease

Types of Leptocytes
- Condocyte (target cell)
- Stomatocytes,
- Knizocyte (Bar cell)
Target cell
condocyte

stomatocyte
barr cell
knizocyte
elliptocyte
- ovalocyte
- liver/kidney disease
eccentrocyte
diabetes/cancer/toxins
dacryocyte
- tear shape
- BM issues
- human error

Basophillic Stippling
- dark speckles
- rumintants/cats with anemia
Howell-Jolly Bodies
- nuclear remnants
- anemia

Heinz Bodies
- pale area
- cancer/hyperthyroidism/diabetes

Mycoplasma haemofelis
- found on membrane
- may trigger immune response
bone marrow not working & non regenerative appearance
- Normocytic
- normochromic
- low PCV
BM responding, regenerative, has reticulocytes
- macrocystic
- polychromic
iron deficiency appearance
- microcytic
- hypochromic
what is macrocytic, normochromic cells
- rare
- caused by genetics, FeLV, B12 deficiency